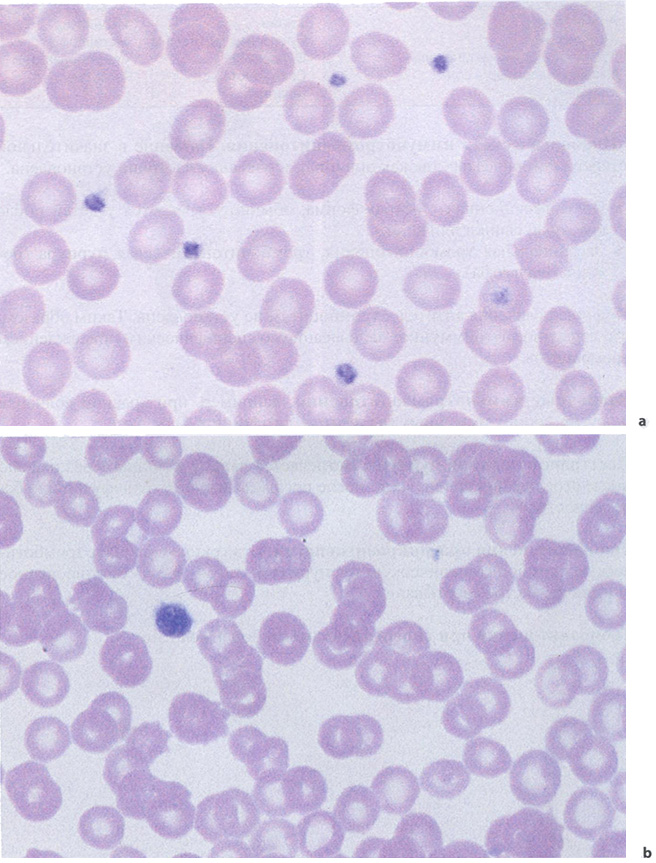
Формы тромбоцитопений

Тромбоцитопения. Аномалии тромбоцитов. Лабораторная диагностика. Лекция для врачей
Лекция для врачей "Тромбоцитопения. Аномалии тромбоцитов. Лабораторная диагностика" (отрывок из книги "Атлас по гематологии" - Тэмл Х., Диам Х., Хаферлах Т.)
Аномалии тромбоцитов
Забор крови в капилляры с ЭДТА может вызвать агрегацию тромбоцитов (псевдотромбоцитопению). Требуется контроль с использованием цитрата в качестве антикоагулянта.
Основанием для подозрения на тромбоцитарные или сосудистые аномалии являются клинические признаки спонтанных кровоизлияний мелкого размера в кожу и слизистые оболочки (петехии), среднего размера - подкожные экхимозы.
Тромбоцитопения
Тромбоцитопении вследствие повышенной потребности в тромбоцитах
Характерным признаком этой патологии может быть то, что среди небольшого количества обнаруженных в мазке крови тромбоцитов увеличено число крупных, т. е. менее зрелых их форм.
При этих тромбоцитопениях в костном мозге увеличено или, по крайней мере, сохраняется в пределах нормы количество мегакариоцитов. Возможно увеличение количества незрелых форм мегакариоцитов с одним или двумя ядрами.
Лекарственно-индуцированная иммунотромбоцитопения. Как и при лекарственно-индуцированных агранулоцитозах, процесс начинается с по-явления антител к лекарственному средству или его метаболитам и образования комплекса антител с тромбоцитами. Происходит быстрая деградация тромбоцитов макрофагами (табл. 29). Наиболее часто индуктором являются анальгетики, противовоспалительные лекарства и антибиотики.
Таблица 29 Наиболее частые причины лекарственно-индуцированной тромбоцитопении

Рис. 59 Формы тромбоцитопений, а В этом препарате крови тромбоциты нормального размера и плотности. Ь В этом препарате крови снижена плотность тромбоцитов, размеры их увеличены, что является характерным признаком тромбоцитопении.
«Идиопатическая» иммунотромбоцитопения. Название в значительной степени историческое, так как причина заболевания частично установлена.
- Постинфекционная - острая форма, обычно встречается у детей после краснухи, свинки или кори.
- Эссенциальная тромбоцитопения, тромбоцитопеническая пурпура (болезнь Верльгофа).
Причина появления антител к тромбоцитам не установлена. Таким образом, это первичное аутоиммунное заболевание со специфическим повреждением тромбоцитов.
Вторичные иммунотромбоцитопении, например, при красной волчанке и других формах иммунных васкулитов, лимфом и туберкулезе.
Посттрансфузионная пурпура. Встречается чаще у женщин через неделю после переливания крови, часто после предшествующих трансфузий или беременности.
Тромбоцитопения при микроангиопатии. Эта группа включает тромботическую тромбоцитопеническую пурпуру и диссеминированное внутрисосудистое свертывание.
Тромбоцитопения при гиперспленизме любой этиологии.
Вы читали отрывок из книги "Атлас по гематологии" - Тэмл Х., Диам Х., Хаферлах Т.
Купить книгу "Атлас по гематологии" - Тэмл Х., Диам Х., Хаферлах Т. в интернет-магазине shopdon.ru
Дополнительный материал
Лимфомы, сопровождающиеся спленомегалией. Лабораторная диагностика
Острые лейкозы (лейкемии). Лабораторная диагностика
Хронический лимфолейкоз. Лабораторная диагностика
Книга "Атлас по гематологии"
Авторы: Тэмл Х., Диам Х., Хаферлах Т.

В атласе рассмотрена морфология клеток крови в норме и при различных патологических состояниях. В нем также содержатся элементарные сведения по выполнению и трактовке результатов цитологического исследования костного мозга, лимфатических узлов, других органов и тканей. Атлас иллюстрирован информативными микрофотографиями, которые сопровождаются пояснениями, основанными на современных принципах и критериях морфологической классификации.
Нозология и дифференциальная диагностика болезней системы крови нашли свое отражение в соответствующих таблицах. Структура представленного в атласе материала базируется на системном подходе к различным разделам лабораторной гематологии.
Издание будет полезно врачам-лаборантам, врачам общей практики и студентам медицинских вузов старших курсов.
Купить книгу "Атлас по гематологии" - Тэмл Х., Диам Х., Хаферлах Т. в интернет-магазине shopdon.ru
Содержание книги "Атлас по гематологии" - Тэмл Х., Диам Х., Хаферлах Т.
Цели и задачи
Схема изложения и структура построения атласа
Инструкция по использованию атласа.
Благодарности
Физиология и патофизиология клеток крови.
Лабораторные методы и тесты
Введение в физиологию и патофизиологию системы кроветворения
Клеточные системы
Принципы регуляции и дизрегуляции системы крови и их диагностическое значение
Методы, материал для исследований, нормальные значения показателей лабораторных тестов
Взятие проб крови
Подсчет количества эритроцитов
Определение гемоглобина и гематокрита
Определение параметров эритроцитов
Распределение эритроцитов по объему (RDW анизотропии эритроцитов)
Подсчет количества ретикулоцитов
Подсчет количества лейкоцитов
Подсчет количества тромбоцитов
Нормальные значения содержания клеточных компонентов крови
Мазок крови и его интерпретация (дифференциальный подсчет клеток)
Использование гематологических анализаторов для оценки морфологической картины крови
Биопсия костного мозга
Биопсия лимфоузла и биопсия опухоли
Этапы диагностического исследования
Клетки крови и гемопоэтических органов в норме.
Клетки гемопоэза
Клетки-предшественники эритропоэза: проэритробласты и базофильные эритробласты
Созревающие клетки-предшественники красного ряда: полихроматофильные и оксифильные эритробласты (нормобласты) и ретикулоциты
Клетки-предшественники гранулоцитов: миелобласты и промиелоциты
Созревающие клетки-предшественники гранулоцитов: миелоциты и метамиелоциты
Зрелые нейтрофилы: палочкоядерные и сегментоядерные нейтрофилы
Дегенеративные изменения клеток, патологическая зернистость, ядерные «придатки» в нейтрофильных гранулоцитах и ядерные аномалии.
Эозинофильные гранулоциты (эозинофилы)
Базофильные гранулоциты (базофилы)
Моноциты
Лимфоциты и плазматические клетки
Мегакариоциты и тромбоциты
Костный мозг: клеточный состав и принципы исследования
Костный мозг: клетки стромы костного мозга
Аномалии клеток белого ряда
Преобладание мононуклеаров с ядрами круглой или овальной формы
Реактивный лимфоцитоз
Инфекционный мононуклеоз как пример чрезвычайно выраженной
стимуляции лимфоцитов
Заболевания лимфоидной системы (неходжкинские лимфомы)
Дифференциация лимфоидных клеток и клеток НХЛ с помощью выявления экспрессии поверхностных маркеров
Хронический лимфолейкоз (ХЛЛ) и его варианты
Купить книгу "Атлас по гематологии" - Тэмл Х., Диам Х., Хаферлах Т. в интернет-магазине shopdon.ru
Лимфоплазмоцитарная лимфома
Лимфомы, факультативно протекающие с лейкемизацией (например, лимфома из клеток мантийной зоны и фолликулярная лимфома)
Лимфомы, обычно сопровождающиеся спленомегалией (например, волосатоклеточный лейкоз и лимфома селезенки из ворсинчатых лимфоидных клеток)
Моноклональная гаммапатия (гипергаммаглобулинемия), множественная миелома, плазмоклеточная миелома, плазмоцитома
Морфологические варианты плазмоцитомы
Относительные лимфоцитозы при гранулоцитопении (нейтропении) и агранулоцитозе
Классификация нейтропений и агранулоцитозов
Моноцитоз
Острые лейкозы (лейкемии)
Морфологическая и цитохимическая идентификация клеток
Острые миелоидные лейкозы (ОМЛ).
Острый эритролейкоз (тип М6 по ФАБ-классификации)
Оcтрый мегакариобластный лейкоз (тип М7 по ФАБ-классификации)
ОМЛ с дисплазией
ОМЛ с гипоплазией
Острый лимфобластный лейкоз (ОЛЛ)
Миелодисплазия (МДС)
Увеличение количества полунуклеарных (сегментоядерных) клеток
Нейтрофилез без сдвига влево
Реактивный сдвиг влево
Хронический миелолейкоз и миелопролиферативные синдромы (хронические миелопролиферативные заболевания, ХМПЗ)
Этапы диагностики хронического миелолейкоза
Бластный криз при хроническом миелолейкозе
Остеомиелосклероз
Увеличение количества эозинофилов и базофилов
Аномалии эритроцитов и тромбоцитов.
Клиническая классификация анемий по среднему содержанию гемоглобина в эритроците (МСН)
Гипохромные анемии
Железодефицитная анемия
Гипохромные анемии при инфекциях или интоксикациях (вторичные анемии)
Цитологическое исследование костного мозга при диагностике гипохромных анемий
Гипохромные сидероахрестические анемии (нормохромные или гиперхромные)
Гипохромная гемолитическая анемия
Талассемии
Нормохромные анемии
Нормохромные гемолитические анемии
Цитоморфологическая характеристика анемий с аномалиями эритроцитов
Нормохромная почечная анемия (гипохромная или гиперхромная)
Аплазия костного мозга
Парциальная красноклеточная аплазия (ПКА, эритробластопения)
Аплазия всех рядов костного мозга (панмиелопатия, панмиелофтиз, апластическая анемия).
Карциноматоз костного мозга и другие метапластические процессы
Гиперхромные анемии
Включения в эритроцитах
Гематологический диагноз малярии
Истинная полицитемия (эритремическая полицитемия) и эритроцитозы
Аномалии тромбоцитов
Тромбоцитопения
Тромбоцитопении вследствие повышенной потребности в тромбоцитах
Тромбоцитопении вследствие сниженной продукции тромбоцитов
Тромбоцитозы (в том числе эссенциальная тромбоцитемия)
Эссенциальная (идиопатическая) тромбоцитемия
Цитологическое исследование биоптатов органов и экссудатов
Цитологическое исследование лимфатического узла
Реактивная гиперплазия лимфатического узла и лимфогранулематоз (болезнь Ходжкина)
Саркоидоз и туберкулез
Неходжкинская лимфома
Метастазы солидных опухолей в лимфатические узлы или подкожные ткани
Бранхиогенные кисты и бронхоальвеолярный лаваж
Бранхиогенные кисты
Цитологическое исследование органов дыхания, в частности бронхоальвеолярный лаваж
Цитологическое исследование плевральных выпотов и асцитической жидкости.
Цитологическое исследование цереброспинальной жидкости
Купить книгу "Атлас по гематологии" - Тэмл Х., Диам Х., Хаферлах Т. в интернет-магазине shopdon.ru
0 комментариев